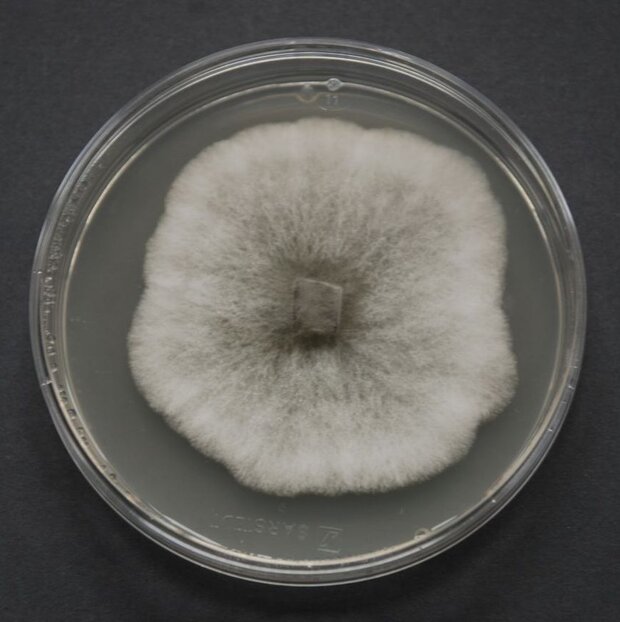
Petrischale mit Reinkultur von Sphaeropsis sapinea (Erreger des Diplodia-Triebsterbens)

Abgeschlossene Projekte
WAHYKLAS
Waldhygienische Anpassungsstrategien für das steigende Potenzial von Schadorganismen in vulnerablen Regionen unter Berücksichtigung von Klimawandel und zunehmenden Restriktionen

Das Projekt WAHYKLAS ist als grundlagen- und anwendungsorientiertes Forschungsvorhaben in einem kooperativen Verbund verschiedener Landes- und übergeordneter Forschungsinstitutionen geplant und entwickelt. Darüber hinaus wird eine enge Zusammenarbeit mit den lokalen und regionalen forstlichen Betriebseinrichtungen sowohl öffentlich-rechtlicher als auch privatwirtschaftlicher Organisationseinheiten angestrebt.
Es wird gefördert aus dem Sondervermögen "Energie- und Waldklimafonds" im Rahmen der Richtlinie zur Förderung von Maßnahmen zum Erhalt- und Ausbau des CO2-Minderungspotenzials von Wald und Holz sowie zur Anpassung der Wälder an den Klimawandel (Förderrichtlinie Waldklimafonds).
Das Verbundprojekt zielt ab auf die Entwicklung nachhaltiger, waldhygienischer Konzepte am Beispiel ausgewählter Vergleichsregionen Deutschlands, für die eine hohe Vulnerabilität durch die Effekte des Klimawandels, die zunehmende Globalisierung sowie durch die Bildung bzw. Ausweitung von Ballungszentren besteht oder für die Zukunft erwartet wird. Die Vulnerabilität der einbezogenen Regionen orientiert sich dabei vor allem an der vergleichsweise begrenzten pflanzenverfügbaren Niederschlagsmenge sowie an dem prognostizierten Temperaturanstieg. Das Wachstum und die Vitalität der Bäume sind sowohl direkt (z. B. Wassermangel) als auch indirekt (z. B. Anfälligkeit gegenüber Schaderregern) beeinträchtigt. Insbesondere der Temperaturanstieg ermöglicht einerseits gebietsfremden, wärmeliebenden Schadorganismen die Einwanderung bzw. Etablierung. Andererseits führt er bei einer Reihe heimischer Pilz- und Insekten-Arten mit phytosanitärer Bedeutung zu einer Beschleunigung der Entwicklungsprozesse.
Projektkoordination des Verbundprojekts:
Die Koordination des Verbundprojektes mit 13 geplanten wissenschaftlichen Teilprojekten (TP) und 9 Projektpartnern (PP) erfolgt durch die Forstliche Versuchs- und Forschungsanstalt Baden-Württemberg (FVA) in Freiburg.
Die Abteilung Waldschutz der NW-FVA (Projektpartner 2) ist mit folgenden Teilprojekten beteiligt:
TP 3: Retrospektive Arealanalyse der wichtigsten Schaderreger und deren Populationsdynamik an den ökologisch und ökonomisch bedeutendsten Baumarten (Eichen und Kiefern) und Gefährdungsanalyse für potenzielle und standortgerechte Baumarten (Sachgebiet Schmetterlinge / Mäuse)
TP 9: Screening auf Befall und endophytische Durchseuchung der Kiefer mit Sphaeropsis sapinea sowie krankheitsauslösende Faktoren in der Pilz-Wirt-Interaktion (Sachgebiet Mykologie / Komplexerkrankungen)
- Projektpartner 1: Forstliche Versuchs- und Forschungsanstalt Baden-Württemberg in Freiburg i. Br., Abteilung Waldschutz (Verbundprojektkoordination TP 1, TP 7, Koordination)
- Projektpartner 2: Nordwestdeutsche Forstliche Versuchsanstalt (NW-FVA) in Göttingen (TP 3, TP 9)
- Projektpartner 3: Bayerische Landesanstalt für Wald und Forstwirtschaft (LWF) in Freising (TP 5)
- Projektpartner 4: Landeskompetenzzentrum Forst Eberswalde (LFE) für Brandenburg (TP 4, TP 10)
- Projektpartner 5: Forschungsanstalt für Waldökologie und Forstwirtschaft (FAWF) in Trippstadt
- Projektpartner 6: ThüringenForst AöR, Service- und Kompetenzzentrum Gotha
- Projektpartner 7: Albert-Ludwigs-Universität Freiburg (Universität Freiburg, Institut für Forstwissenschaften, Professur für Baumphysiologie) (TP 2, TP 8)
- Projektpartner 8: Potsdam-Institut für Klimafolgenforschung (PIK, Forschungsbereich II: Klimawirkung und Vulnerabilität) (TP 6, TP 11, TP 12, TP 13)
- Projektpartner 9: Humboldt-Universität zu Berlin (HU Berlin, Geographisches Institut)
Das Projekt WAHYKLAS wird unter dem Förderkennzeichen 28WC403102 vom Bundesministerium für Ernährung und Landwirtschaft (BMEL) und vom Bundesministerium für Umwelt, Naturschutz, Bau und Reaktorsicherheit (BMUB) im Rahmen der Fördermaßnahme Waldklimafonds gefördert. Projektträger ist die Bundesanstalt für Landwirtschaft und Ernährung (BLE).


Bußkamp J., Langer G., Potsdam-Institut für Klimafolgenforschung (2018): Diplodia-Triebsterben - ein neues Phänomen? In: Klimawandel, Stadtwald, Schaderreger. S. 9-11.
Hu B., Sakakibara H., Kojima M., Takebayashi Y., Bußkamp J., Langer G. J., Peters F. S., Schumacher J., Eiblmeier M., Kreuzwieser J., Rennenberg H. (2017): Consequences of Sphaeropsis tip blight disease for the phytohormone profile and anti-oxidative metabolism of its pine host. Plant Cell Environ., 1-18. (onlinelibrary.wiley.com/doi/10.1111/pce.13118/abstract)
